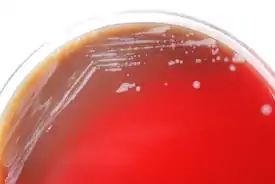

Burkholderia mallei
Burkholderia mallei (лат.) — вид полиморфных грамотрицательных неподвижных бактерий рода буркхольдерий (Burkholderia). Возбудитель сапа, патогенен для человека и животных (лошади, мулы). Используется как биологическое оружие, потенциальный объект биотерроризма, отнесён ко II группе патогенности.
| Burkholderia mallei | ||||||||||
|---|---|---|---|---|---|---|---|---|---|---|
Колонии Burkholderia mallei на кровяном агаре | ||||||||||
| Научная классификация | ||||||||||
|
Домен: Тип: Класс: Бета-протеобактерии Порядок: Burkholderiales Семейство: Burkholderiaceae Род: Буркхольдерии Вид: Burkholderia mallei |
||||||||||
| Международное научное название | ||||||||||
|
Burkholderia mallei (Zopf 1885) Yabuuchi et al. 1993 |
||||||||||
| ||||||||||
Систематика
Возбудитель сапа был открыт в 1882 году Фридрихом Лёффлером (нем. Friedrich August Johannes Loeffler, 1852—1915), описана немецким ботаником и биологом Фридрихом Цопфом (1846—1909) в 1885 году под названием «Bacillus mallei». В 1966 году бактерия была перенесена в род Pseudomonas на базе особенностей пищевых потребностей и биохимических свойств. В 1973 году Пеллерони (Palleroni) по данным РНК-ДНК гибридизации разделил род Pseudomonas на 5 групп гомологии, где Pseudomonas mallei была включена в группу II. В 1993 году Yabuuchi, Kosako, Oyaizu, Yano, Hotta, Hashimoto, Ezaki и Arakawa на основании данных анализа 16S рРНК, ДНК-ДНК гибридизации и состава жирных кислот клеточной стенки выделили все семь видов группы гомологии II в отдельный род Burkholderia[1]. Burkholderia mallei очень близка к Burkholderia pseudomallei и Burkholderia thailandensis.
Биологические свойства
Морфология
Burkholderia mallei представляет собой прямую или слегка изогнутую палочковидную бактерию 2—5 × 0,5—0,8 мкм. Не образует капсул и спор, неподвижна.
Культуральные свойства
Хемоорганогетеротроф, облигатный аэроб. Растёт на простых питательных средах, в особенности с добавками глицерина. На агаризованных питательных средах плоские гладкие слизистые серые колонии, на агаре Мак Конки нет роста либо белые-розоватые колонии[2][3].
Геном
Геном B. mallei обладает высокой пластичностью за счёт наличия большого числа IS-элементов, микросателлитов (SSR) (более 12000) и массивных геномных перестроек[4]. Определённую роль в эволюции B. mallei как патогенного для животных и человека микроорганизма сыграли потери генов[5]. Определена нуклеотидная последовательность геномов некоторых штаммов B. mallei. Геном B. mallei штамма ATCC 23344 представлен двумя хромосомами. Хромосома I представляет собой кольцевую двуцепочечную молекулу ДНК размером 3510148 п.н. и содержит 3393 генов, из которых 2995 кодируют белки[6]. Хромосома II представляет собой кольцевую двуцепочечную молекулу ДНК размером 2325379 п.н. и содержит 2115 генов, из которых 2029 кодируют белки[7]. B. mallei штамм NCTC 10229 содержит 2 двуцепочечные кольцевые хромосомы размером 3458208 и 2284095 п.н. и содержат соответственно 3409 и 2215 генов, из которых 3333 на хромосоме I и 2177 на хромосоме II кодируют белки[8][9].
Патогенность
B. mallei патогенна для человека и животных, является возбудителем зоонозной антропоургической инфекции — сапа. При сапе в органах и тканях поражённого организма образуются специфические гранулёмы, пустулы и абсцессы. B. mallei способна синтезировать белки, связывающиеся с актином[10]. Значение для патогенеза имеет способность к синтезу внеклеточных полисахаридов[11]. B. mallei обладает резистентностью к некоторым антибиотикам[12][13]. Ввиду высокой патогенности для человека и животных B. mallei использовалась в качестве биологического оружия во времена гражданской войны в Америке, а также в I и II мировых войнах[14] и является потенциальным агентом биотерроризма[15]. Отмечены случаи внутрилабораторного заражения[16].
Примечания
- Yabuuchi E., Kosako Y., Oyaizu H., Yano I., Hotta H., Hashimoto Y., Ezaki T. et Arakawa M. Proposal of Burkholderia gen. nov. and transfer of seven species of the genus Pseudomonas homology group II to the new genus, with the type species Burkholderia cepacia (Palleroni and Holmes 1981) comb. nov.// Microbiol. Immunol., 1992, № 36, 1251—1275.
- Pennsylvania Department of Health (недоступная ссылка). Дата обращения: 16 августа 2008. Архивировано 31 марта 2010 года.
- Hawaii State Department of Health
- http://www.pnas.org/content/101/39/14246.full.pdf
- Contribution of Gene Loss to the Pathogenic Evolution of Burkholderia pseudomallei and Burkholderia mallei
- uid=499 Genome Result
- uid=500 Genome Result
- uid=20328 Genome Result
- uid=20326 Genome Result
- The Search Engine that Does at InfoWeb.net (недоступная ссылка)
- Identification of a Burkholderia mallei polysaccha… [Microb Pathog. 2001] — PubMed result
- Antibiotic susceptibility of 65 isolates of Burkho… [J Antimicrob Chemother. 2004] — PubMed result
- In vitro susceptibilities of Burkholderia mallei in comparison to those of other pathogenic Burkholderia spp (недоступная ссылка). Дата обращения: 16 августа 2008. Архивировано 2 января 2009 года.
- Burkholderia mallei | Bacteria | Karyn’s Genomes | 2can Support Portal | EBI
- ההסתדרות הרפואית בישראל (недоступная ссылка). Дата обращения: 16 августа 2008. Архивировано 26 декабря 2010 года.
- Laboratory-acquired human glanders-Maryland, May … [MMWR Morb Mortal Wkly Rep. 2000] — PubMed result
Ссылки
- Burkholderia mallei.
- Burkholderia Yabuuchi et al. 1993.
- Burkholderia mallei Pathogen information.
- Genome Project > Burkholderia mallei.
- Burkholderia Genome Database.
- Bioterrorism Agent Fact Sheet Glanders/Burkholderia mallei.
- Burkholderia mallei и Burkholderia pseudomallei. Изучение иммуно- и патогенеза сапа и мелиоидоза. Гетерологичные вакцины.